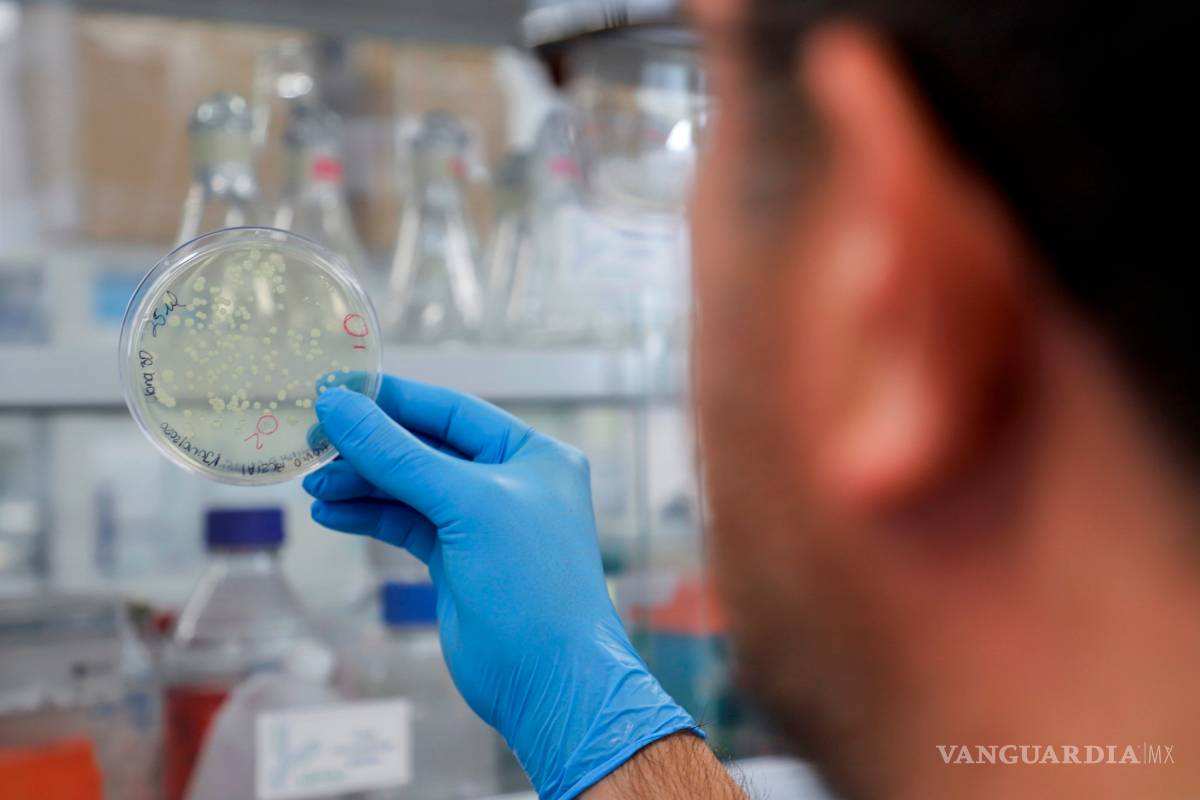

Ssa: Vacuna mexicana podría quedar este año
COMPARTIR
Se trata del esfuerzo que ha arrancado la Universidad Autónoma de Querétaro, que está avanzando y se encamina hacia los ensayos clínicos
CDMX.- Antes de que termine el año, el País podría contar con su propia vacuna contra el COVID-19 desarrollada por científicos mexicanos, adelantó el secretario de Salud (Ssa), Jorge Alcocer Varela.
Se trata del esfuerzo que ha arrancado la Universidad Autónoma de Querétaro, que está avanzando y se encamina hacia los ensayos clínicos.
Durante la primera reunión ordinaria del Consejo Nacional de Salud (Conasa), el titular de la Ssa dijo que esto se ha logrado en tiempo acelerado en un proceso inmediato para poder desarrollar las vacunas con seguridad, eficiencia y eficacia.
“En todos lados y en nuestro país se ha logrado iniciar la participación científica para la búsqueda de esta vacuna en meses, posiblemente antes de que termine este año será posible contar con una vacuna hecha en México”.
El director general de Promoción de la Salud, Ricardo Cortés Alcalá, dijo que la vacuna ha tenido algunos avances y que se está buscando que tenga múltiples fuentes de financiamiento a través de Amexcid.








